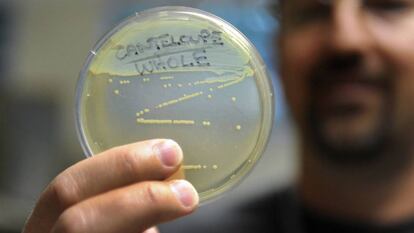

Muere una anciana de 90 años por el brote de listeriosis en Andalucía
Los afectados ascienden a 114 en la comunidad. Se investigan un caso en Madrid y otros cuatro en Extremadura. La carne contaminada se distribuyó por Castilla-La Mancha y Tenerife en cantidades mínimas

El brote de listeriosis originado en Andalucía sigue sin control y se ha cobrado la vida de una mujer de 90 años en Sevilla la pasada madrugada, han informado las autoridades sanitarias de la comunidad. Se trata de la primera víctima mortal por el peor brote de esta infección en España, que afecta ya a 114 personas en esta comunidad, de las cuales 53 están hospitalizadas, entre ellas 18 mujeres embarazadas y dos recién nacidos. La mujer ingresó el 15 de agosto en el hospital Virgen del Rocío y llevaba al menos cuatro días con síntomas.
En menos de 24 horas se han confirmado 34 nuevos casos en Andalucía. Los expertos coinciden en que para determinar la evolución de un brote de listeriosis es importante conocer el incremento diario de afectados. El lunes, la Consejería de Salud confirmó un incremento de casi 40 personas. Solo cuando las diferencias son de tres o cuatro personas puede darse el brote por controlado.
Sanidad investiga también un posible caso de la enfermedad, originada por el consumo de carne mechada contaminada (La Mechá), en Madrid y cuatro en Extremadura, que se sumarían al ya diagnosticado en esta comunidad, según ha informado la ministra de Sanidad, María Luisa Carcedo, en el programa Hoy por hoy de la cadena SER, quien ha revelado también que cantidades mínimas de la carne mechada causante del brote han llegado a Castilla-La Mancha y Tenerife. La Junta de Castilla y León ha decretado la alerta sanitaria esta tarde al detectar cuatro envases de la carne contaminada en un establecimiento de la localidad segoviana de San Rafael.
Y la a Agència de Salut Pública de Catalunya (Aspcat) informa en un comunicado que ha recibido este martes a mediodía la notificación de una "sospecha clínica" de dos personas posiblemente afectadas por listeriosis y que pueden estar relacionadas con el brote de Andalucía. Se trata de dos personas de una misma familia residentes en Cataluña que recibieron hace unos días la visita de otro familiar procedente de Sevilla. Éste les trajo carne mechada de la marca causante de los casos en Andalucía y los tres la consumieron, según ha informado la Generalitat. Días después de comerla, empezaron a sufrir diarreas, fiebres y dolor en las articulaciones, de los que ya están recuperados.
La Consejería andaluza de Salud y Familias, a través del procedimiento habitual para alertas alimentarias a nivel nacional establecido en el Sistema Coordinado de Intercambio Rápido de Información (Sciri), ha trasladado toda la información disponible a la Agencia Española de Seguridad Alimentaria y Nutrición (Easan).
La listeriosis es una infección causada por la bacteria Listeria monocytogenes, común en el medio ambiente que llega al organismo a través de alimentos contaminados. Aunque en la mayoría de personas sanas cursa de forma asintomática o con cuadros leves —trastornos digestivos, fiebre...—, la listeria puede ser muy grave e incluso mortal en personas mayores y con el sistema inmunológico debilitado. La bacteria también es peligrosa durante el embarazo y para el recién nacido, ya que en estos casos puede causar abortos, muerte fetal y graves secuelas al bebé incluso cuando la madre cursa la infección sin sufrir trastorno alguno. La consejería de Salud investiga si los abortos sufridos por dos mujeres en los últimos días están relacionados con el brote.
La mayoría de los hospitalizados andaluces se encuentran en Sevilla (35), y también hay ingresados en Huelva (7), Málaga (6) y Cádiz (5). El médico José Miguel Cisneros, portavoz del grupo para el control de la crisis organizado por la Consejería de Salud, ha hecho hincapié en que la mujer fallecida entraba dentro del grupo de pacientes de riesgo, junto con las embarazadas y las personas con enfermedades crónicas y los niños. La enferma fallecida estaba ingresada a causa de la infección causada por la bacteria, que derivó en una meningoencefalitis. Permanecía ingresada en la UCI del hospital hispalense y pasó a cuidados paliativos el pasado viernes, según ha informado la Consejería andaluza de Salud. La primera víctima del brote acudió al centro médico después de estar cuatro o cinco días con síntomas, lo que complicó el tratamiento.
Cisneros ha insistido en la importancia de que todas aquellas personas que hayan ingerido la carne mechada que ha originado la alerta sanitaria acudan a los hospitales en cuanto presenten síntomas. "El tratamiento es muy eficaz", ha asegurado.
Dos de las cuatro personas en estudio en Extremadura consumieron carne mechada de la marca La Mechá en Andalucía al igual que en el caso que ya está confirmado en esta comunidad, mientras que los otros dos parecen corresponder a episodios esporádicos de los que anualmente registra la región, según informa Efe. De estas cinco personas, tres ya han recibido el alta hospitalaria —dos en Llerena y uno en Badajoz— y los otros dos, que se encuentran ingresados en el Hospital de Mérida, se prevé que puedan obtenerla a lo largo de este martes, ha informado el consejero de Sanidad, José María Vergeles
La carne mechada La Mechá se distribuyó en Andalucía, Extremadura y Madrid, según Carcedo. "Había otras destinadas a Cataluña que permanecen en una plataforma de distribución y no han llegado a su destino", precisó. "Se han inmovilizado todos los lotes de carne a partir del mes de mayo para prevenir cualquier tipo de riesgo".
La ministra ha asegurado en la cadena SER que la red de alerta nacional está activada en toda España desde que Andalucía la declaró. Además, por una doble vía: a través de la red de seguridad alimentaria y la red de vigilancia epidemiológica.
"Se trata de que no se extienda la carne. Se ha ordenado la retirada de todo este producto de esta fábrica que está cerrada. Luego hay que detener la enfermedad y después entender qué pasó", ha dicho la responsable de Sanidad en funciones.
Cisneros ha querido transmitir un mensaje de tranquilidad a los ciudadanos. "Se producen unos 300 casos de infección por listeriosis al año y muere el 20%. Ahora lo que ocurre es que estamos ante un brote por un alimento contaminado. La mayoría de las personas que hayan tomado ese alimento no debe estar preocupado porque probablemente no tenga síntomas o padezca una gastroenteritis leve".
El médico, director del Servicio de Infecciosos del Hospital Virgen del Rocío de Sevilla, ha restado importancia al riesgo que puede suponer la posibilidad de contaminación cruzada, aquellos casos en los que la carne mechada infectada ha podido entrar en contacto con otros alimentos o utensilios para su corte transmitiendo la bacteria. "Tienen prioridad aquellos afectados que han comido el producto retirado, los demás podrían a no tener síntomas. En los demás casos lo más común es que sufran una gastroenteritis, que no piensen que tienen listeria, será salmonelosis", ha señalado Cisneros.
La Junta no está todavía en disposición de confirmar que los abortos provocados por infección de listeriosis en la placenta estén relacionados con el brote. Cisneros recuerda que la listeriosis es una enfermedad común entre las embarazadas y por eso se les recomienda no comer carne cruda o tomar alimentos pasteurizados.
Cisneros ha asegurado que todos los hospitales andaluces están siguiendo un protocolo estándar para el tratamiento de la listeriosis. Cuando llegan, si no están dentro del grupo de riesgo y presentan síntomas leves se les pone en vigilancia y observación con tratamiento antibiótico. Si están entre el grupo de riesgo se les aplica el tratamiento desde el principio. Los hospitales practican a los pacientes una prueba diagnóstica que tarda un tiempo en dar resultados. Mientras tanto al afectado se le mantiene ingresado o en vigilancia. SI el cultivo es negativo, la media de confirmación es 24 horas y si es positivo puede tardar cuatro o cinco días. Cuando se tiene constancia del resultado se llama al paciente para que siga tomando el antibiótico.
Tu suscripción se está usando en otro dispositivo
¿Quieres añadir otro usuario a tu suscripción?
Si continúas leyendo en este dispositivo, no se podrá leer en el otro.
FlechaTu suscripción se está usando en otro dispositivo y solo puedes acceder a EL PAÍS desde un dispositivo a la vez.
Si quieres compartir tu cuenta, cambia tu suscripción a la modalidad Premium, así podrás añadir otro usuario. Cada uno accederá con su propia cuenta de email, lo que os permitirá personalizar vuestra experiencia en EL PAÍS.
¿Tienes una suscripción de empresa? Accede aquí para contratar más cuentas.
En el caso de no saber quién está usando tu cuenta, te recomendamos cambiar tu contraseña aquí.
Si decides continuar compartiendo tu cuenta, este mensaje se mostrará en tu dispositivo y en el de la otra persona que está usando tu cuenta de forma indefinida, afectando a tu experiencia de lectura. Puedes consultar aquí los términos y condiciones de la suscripción digital.


























































